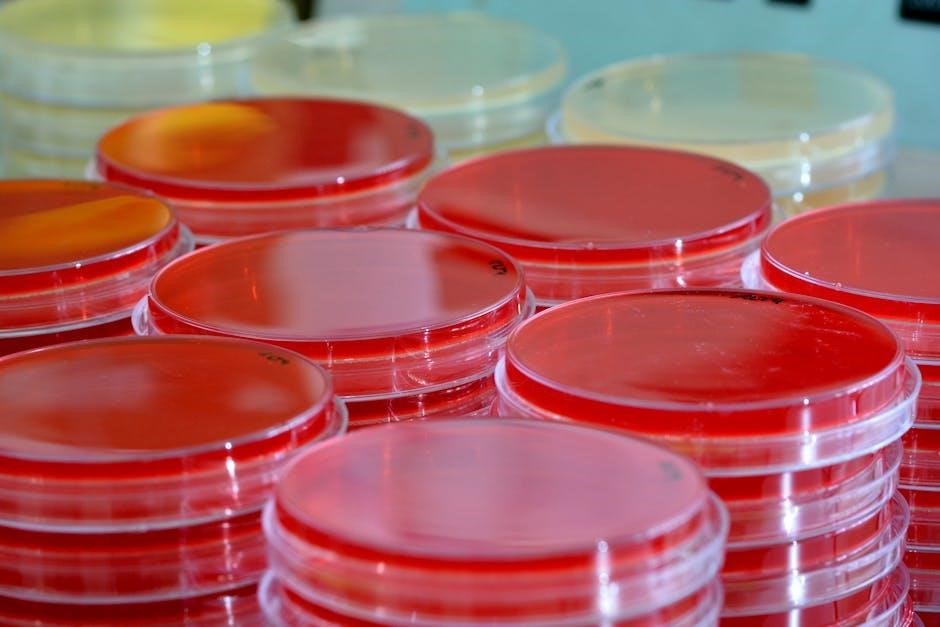

MOT Testing Guide and Inspection Manual: A Comprehensive Overview (Updated 03/23/2026)
Today, March 23rd, 2026, brings clarity for classic car enthusiasts regarding LED bulb installations. Recent MOT updates indicate not all LED conversions
will automatically trigger a test failure, addressing previous anxieties.
What is an MOT Test?
The MOT test, legally mandated in the United Kingdom, is an annual inspection ensuring vehicle roadworthiness and safety. “MOT” stands for Ministry of Transport, though the department responsible has evolved over time. It’s a comprehensive assessment, not a full mechanical service, focusing on components crucial for safe operation on public roads.
Essentially, an MOT verifies that your vehicle meets the minimum acceptable environmental standards and road safety requirements at the time of the test. This includes checks on brakes, tyres, steering, suspension, lights, and emissions. A valid MOT certificate is a legal requirement for most vehicles over three years old.

It’s important to understand that passing an MOT doesn’t guarantee a vehicle is mechanically perfect. It simply confirms it meets the required standards at the time of the test. Issues discovered during an MOT are categorized as ‘Dangerous’, ‘Major’, or ‘Minor’ defects, influencing whether a pass certificate is issued immediately or requires rectification before re-test.
Recent updates, like those concerning LED bulb compatibility, demonstrate the MOT test’s ongoing evolution to reflect modern vehicle technology and safety standards.
MOT Test Eligibility & Vehicle Age
Determining MOT test eligibility hinges primarily on vehicle age and type. Generally, most vehicles require their first MOT test when they reach three years old. This applies to petrol, diesel, and electric cars, as well as light commercial vehicles. However, there are exceptions to this rule.
Vehicles manufactured before 1960 are exempt from the MOT test, reflecting their historical status and differing safety standards. Furthermore, certain vehicles, like those used solely on private land, are also exempt. It’s crucial to verify your vehicle’s specific eligibility based on its registration date and intended use.
Even if a vehicle is exempt, owners are still legally responsible for ensuring it’s roadworthy if driven on public roads. The MOT test isn’t a substitute for regular vehicle maintenance. Understanding these age-related requirements is vital for all vehicle owners.
Recent changes, such as clarifications regarding LED bulb installations, don’t alter the fundamental age-based eligibility criteria but impact how specific components are assessed during the test.
Preparing Your Vehicle for an MOT Test
Thorough preparation significantly increases your vehicle’s chances of passing the MOT test first time. Begin with a comprehensive check of all lights – headlights, indicators, brake lights, and hazard lights – ensuring they function correctly and aren’t cracked or damaged. Verify wiper operation and top up washer fluid levels.
Inspect tyres for adequate tread depth (minimum 1.6mm) and check for any cuts or bulges. Ensure the vehicle’s number plates are clean, legible, and conform to legal standards. A quick visual inspection of the vehicle’s structure for any obvious corrosion or damage is also advisable.
Addressing minor issues beforehand can prevent costly repairs and delays. While a pre-MOT check isn’t mandatory, it’s a prudent step. Remember, the MOT test assesses safety and roadworthiness, not general mechanical condition.
Recent updates regarding LED bulbs mean ensuring they function correctly within legal limits is now a key preparation point, avoiding potential failures.
Common MOT Failure Items – A Statistical Breakdown
Lighting and signalling consistently rank among the top reasons for MOT failures, accounting for approximately 20% of all test failures. Tyre condition closely follows, with around 15% failing due to insufficient tread or damage. Brake-related issues contribute to roughly 10% of failures, encompassing worn pads, discs, or hydraulic problems.
Suspension components, such as worn shock absorbers or ball joints, cause around 7% of failures. Exhaust system defects, including leaks or excessive noise, contribute to approximately 6%. Visibility-related issues, like cracked windscreens or non-compliant number plates, account for 5%.
More recently, issues surrounding incorrectly fitted or non-compliant LED bulbs are becoming increasingly prevalent, though specific failure rates are still being compiled following the updated guidance. Addressing these common faults proactively can significantly improve your vehicle’s chances of passing.
These statistics highlight key areas for vehicle owners to focus on when preparing for an MOT test.
Lighting and Signalling – Detailed Inspection

Headlights undergo rigorous scrutiny, checking for correct beam alignment, functionality of both dipped and main beams, and condition of lenses – cracks or damage are immediate failures. Indicators are assessed for correct operation, colour, and synchronicity; Brake lights must illuminate simultaneously and function correctly when the pedal is depressed.

Rear lights, including position lights and fog lights, are inspected for colour, intensity, and security. Number plate lights must illuminate the plate clearly. The recent updates regarding LED bulbs mean that while not automatically failing, they must meet colour and intensity requirements.
Hazard warning lights are tested for simultaneous operation on all corners. Testers verify that all lights are securely mounted and that wiring is intact, with no exposed conductors. Any non-functioning or damaged lighting components will result in a failure.
Correct colour and intensity are paramount, ensuring visibility and compliance with legal standards.
Brakes – Performance and Condition Checks
Brake performance is evaluated using a roller brake tester, measuring the stopping efficiency of each wheel. Significant imbalances – exceeding 70% difference – constitute a failure. Brake discs are inspected for wear, scoring, and corrosion; excessive wear or damage leads to immediate rejection.
Brake pads are checked for sufficient friction material; minimal remaining material results in failure. Brake lines and hoses are thoroughly examined for leaks, cracks, or corrosion. The brake fluid level is verified, and its condition assessed for contamination.
The parking brake must hold the vehicle stationary on a test slope. ABS (Anti-lock Braking System) functionality is checked where fitted, via the warning light illuminating during system self-check. Any advisory notes regarding brake wear are recorded.
Testers ensure all components operate smoothly and efficiently, guaranteeing driver safety and adherence to legal requirements. A comprehensive brake inspection is crucial for roadworthiness.

Tyre Condition – Legal Requirements and Inspection

Tyre inspections focus on legal tread depth, structural integrity, and correct inflation. The minimum legal tread depth for cars is 1.6mm across the central 75% of the tyre’s width, and around the entire circumference. A tread depth gauge is used for accurate measurement.
Tyre sidewalls are scrutinized for cuts, bulges, or abrasions. Any significant damage compromising the tyre’s structure results in failure. Tyre age is also considered; excessively old tyres, even with sufficient tread, may be deemed unsafe.
Tyre pressure is visually checked for obvious under-inflation. Mismatched tyres on the same axle are a failure, as are tyres not suitable for the vehicle’s speed and load capacity. Run-flat tyres are inspected for damage and correct functionality.
Testers verify compliance with legal standards, ensuring tyres contribute to safe handling and braking. Proper tyre condition is paramount for road safety and preventing accidents.
Steering and Suspension – Key Areas of Focus
Steering and suspension components undergo a thorough examination for wear, damage, and correct operation. This includes checking steering rack, ball joints, track rod ends, and power steering functionality. Excessive play in any of these areas constitutes a failure.
Suspension components like shock absorbers, springs, and suspension arms are inspected for leaks, cracks, or corrosion. Shock absorber performance is assessed, often through a bounce test, to ensure adequate damping control. Bushings are checked for deterioration and excessive movement.

Wheel bearings are examined for play and unusual noises during wheel rotation. Anti-roll bar links and bushes are also scrutinized for wear. The tester will assess the overall stability and handling characteristics, looking for any anomalies.
Properly functioning steering and suspension are vital for vehicle control and safety. Any deficiencies impacting these systems will result in an MOT failure, requiring immediate repair.
Vehicle Structure – Corrosion and Damage Assessment
A critical aspect of the MOT test involves a detailed assessment of the vehicle’s structural integrity. This focuses on identifying excessive corrosion or damage that compromises safety. Key areas include the chassis, body shell, floor, and subframes.
Testers will examine for areas of significant rust, particularly those affecting structural members. Welding repairs must meet specific standards; poorly executed or inadequate repairs will lead to failure. Damage from accidents, such as dents or distortions, is also assessed.
Particular attention is paid to areas prone to corrosion, like wheel arches, sills, and around suspension mounting points. Any corrosion that weakens the structure or poses a risk of penetration is a failure. Sharp edges resulting from damage must be addressed.

The goal is to ensure the vehicle’s structural components can withstand normal use and protect occupants in the event of a collision. Structural failures represent a serious safety hazard.
Exhaust System – Emissions and Safety Checks
The exhaust system undergoes rigorous scrutiny during the MOT test, focusing on both emissions control and structural safety. Testers verify the system is securely mounted, free from leaks, and doesn’t exhibit excessive corrosion.
Emissions testing is a key component, measuring levels of harmful pollutants like carbon monoxide (CO), hydrocarbons (HC), and nitrogen oxides (NOx). Vehicles must meet specified emission limits based on their age and fuel type. Catalytic converters are checked for proper function.
Visual inspection covers the entire system, from the exhaust manifold to the tailpipe. Any significant damage, holes, or cracks will result in failure. The exhaust must not be dangerously close to fuel lines or other components.
Silencers are assessed for effectiveness; excessively noisy exhausts are not permitted. Modifications to the exhaust system must comply with legal requirements. A secure and functioning exhaust system is vital for both environmental protection and passenger safety.
Fuel System – Leaks and Security
The fuel system’s integrity is paramount during an MOT test, with a primary focus on detecting leaks and ensuring secure component mounting. Testers meticulously examine fuel lines, the fuel tank, and the fuel filler cap for any signs of deterioration or leakage.
A thorough visual inspection checks for cracks, chafing, or corrosion on fuel lines. Fuel caps must seal correctly to prevent fuel vapor emissions and spillage. Any noticeable fuel odor indicates a potential leak, leading to immediate failure.
Fuel tanks are inspected for damage and secure attachment. Fuel pumps and fuel filters are also assessed for leaks and proper operation. Modifications to the fuel system must adhere to safety standards.
Connections and fittings are scrutinized to ensure they are tight and secure. The fuel system must operate without any risk of fire hazard. A properly functioning and leak-free fuel system is crucial for vehicle safety and environmental responsibility.

Wipers and Washers – Operational Effectiveness
Effective windscreen visibility is critical for safe driving, making the wiper and washer system a key MOT test component. Testers assess both the wipers’ ability to clear the windscreen and the washer system’s functionality.
Wiper blades are examined for damage, such as tears or cracks, and their ability to provide a clean sweep across the windscreen. Excessive streaking or areas of uncleared glass result in failure. The wiper arms must also operate smoothly and securely.
The washer system is tested to ensure it delivers sufficient washer fluid to the windscreen, effectively removing dirt and grime. The fluid reservoir must be adequately filled, and the jets correctly aimed.
Operation of the switch controlling the wipers and washers is also verified. Any malfunction, such as intermittent operation or complete failure, will lead to an MOT test failure. A fully functional system is essential for maintaining clear visibility in all weather conditions.
Seatbelts – Functionality and Condition
Seatbelts are vital safety devices, and their correct operation is rigorously checked during the MOT test. Every seatbelt in the vehicle, including those in the rear, is subject to detailed inspection to ensure passenger safety.
The condition of the webbing is carefully examined for any signs of damage, such as cuts, fraying, or excessive wear. Any visible defects compromising the belt’s integrity will result in failure. Buckles and release mechanisms are tested for smooth and secure operation.
Pretensioners and load limiters, if fitted, are also inspected to confirm they function correctly. These devices play a crucial role in minimizing injury during a collision. The seatbelt must retract fully and lock securely when pulled sharply.
Anchorages are checked for security and integrity, ensuring the seatbelts are firmly attached to the vehicle’s structure. Any loose or damaged anchorages pose a significant safety risk and will cause a test failure. A fully functioning seatbelt system is non-negotiable.
Number Plates – Compliance and Visibility
Number plates are a crucial element of vehicle identification and must adhere to strict legal standards for an MOT pass. Testers meticulously check for compliance with regulations regarding character size, spacing, and font style.
The correct typeface is essential; a prescribed font must be used, and characters must be clearly legible from a specified distance. Plates must not be damaged, faded, or altered in any way that obscures the registration number. Reflective material is also a key requirement.
Spacing between characters and between the letters and numbers is carefully measured to ensure it falls within the permitted limits. Incorrect spacing can lead to a failure. Plates must also display the correct format for the vehicle’s age.
Obstructed or obscured plates will automatically result in a failure. This includes anything that prevents clear visibility of the registration number, such as dirt, damage, or unauthorized additions. Plates must be securely fixed to the vehicle.
Vehicle Identification Number (VIN) Verification
The Vehicle Identification Number (VIN) is a unique 17-character code acting as the vehicle’s fingerprint, and its verification is a standard part of the MOT test. Testers confirm the VIN is present and legible on the vehicle itself, typically located on the dashboard or in the engine bay.
Crucially, the VIN is checked against the vehicle’s documentation – the V5C registration document – to ensure they match exactly. Any discrepancies, even minor ones, will result in an MOT failure, raising concerns about vehicle legitimacy.
Testers also examine the VIN for signs of tampering or alteration. Any evidence of manipulation, such as grinding or welding, is a serious issue and will lead to a failure, potentially indicating vehicle theft or cloning.
The VIN’s physical condition is assessed; it must be clearly visible and not obscured by damage or repairs. If the VIN is unreadable due to corrosion or other issues, the vehicle will fail the test until it’s properly restored.
Recent Changes: LED Bulbs and MOT Testing
Historically, the installation of LED bulbs in vehicles designed for halogen or incandescent lamps often resulted in automatic MOT failure. This was due to concerns regarding light colour, intensity, and potential glare for other road users. However, recent updates to the MOT inspection manual, effective as of today, March 23rd, 2026, have introduced more nuance.
The current guidance clarifies that not all LED conversions will automatically lead to failure. Testers will now assess the overall performance and compliance of the lighting system, rather than simply the bulb type.
Key considerations include whether the LED bulbs produce the correct colour (white or yellow, as specified by regulations) and if the light output falls within acceptable limits. Excessive glare remains a failure point.
Classic car owners are particularly impacted by this change, as they often seek to upgrade their lighting systems with LEDs. The updated rules offer greater flexibility, but compliance with colour and intensity standards is still paramount.
The MOT Inspection Manual – Where to Find It
For comprehensive details regarding the MOT testing process, the official MOT Inspection Manual is the definitive resource. This document outlines the precise standards and procedures that testers must follow during an inspection, ensuring consistency and accuracy across all test centres.
The most up-to-date version of the manual is readily accessible online through the Gov.UK website. A direct link can be found on the official MOT information pages, guaranteeing access to the latest revisions and amendments. It’s crucial to consult the current version, as regulations are periodically updated.
The manual is a detailed and technical document, covering every aspect of the MOT test, from lighting and brakes to steering and emissions. It’s not necessarily designed for casual reading, but it provides invaluable insight for vehicle owners seeking a thorough understanding of the inspection process.
Professional MOT testers are required to be fully conversant with the contents of the manual, and regular training is provided to ensure they remain up-to-date with any changes.
Appealing an MOT Test Result
If you disagree with the outcome of your MOT test, you have the right to appeal the decision. However, the appeals process is structured and requires specific steps to be followed correctly. Initially, it’s best to discuss your concerns directly with the MOT test centre, seeking clarification on the reasons for the failure.
If you remain dissatisfied after speaking with the tester, you can lodge a formal appeal with the Driver and Vehicle Standards Agency (DVSA). This must be done without delay, and it’s advisable to gather any supporting evidence, such as repair invoices or expert opinions.
The DVSA will then investigate your appeal, potentially requesting further information from the test centre or arranging a re-test of your vehicle. It’s important to note that appealing doesn’t automatically guarantee a successful outcome; the DVSA will make an independent assessment based on the evidence presented.
Detailed guidance on the appeals process, including the necessary forms and contact information, is available on the Gov.UK website;



